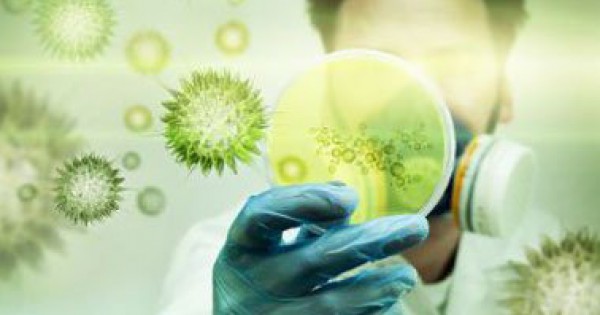

السعودية: وفاة خمسة اشخاص جدد بفيروس كورونا
رام الله - دنيا الوطن
أعلنت السعودية وفاة خمسة اشخاص بفيروس كورونا مما يرفع عدد الذى اودى الفيروس بحياتهم الى 168 شخصا فى المملكة اول بؤرة ظهر فيها مصابون به فى 2012.
وفى حصيلتها الاخيرة التى وضعت السبت على موقعها الالكتروني، قالت وزارة الصحة السعودية ان عدد المصابين بالفيروس المسبب لمتلازمة الشرق الاوسط التنفسية بلغ 529 منذ ظهور المرض فى المملكة. وقالت الوزارة ان رجلين فى السابعة والستين من العمر وسيدة فى الثمانين توفوا فى جدة (غرب) العاصمة الاقتصادية للمملكة حيث اثار الاعلان عن عدة حالات مؤخرا هلعا بين السكان وادى الى اقالة مدير مستشفى الملك فهد.
وتوفى رجل فى الحادية والسبعين وآخر فى السابعة والسبعين فى الرياض والمدينة المنورة (غرب) على التوالى.
وعلاوة على السعودية، سجلت اصابات فى الاردن ومصر ولبنان والامارات والولايات المتحدة وهولندا الا ان غالبية المصابين سافروا الى المملكة او عملوا فيها، والاربعاء اعلنت منظمة الصحة العالمية بعد اجتماع طارىء عقدته الثلاثاء حول كورونا ان لا ضرورة لاعلان حالة "طوارىء صحية عامة شاملة"، فى غياب ادلة حول انتقال الفيروس بين البشر.
واكدت المنظمة ان لجنة الطوارىء التى عقدت اجتماعها الرابع حول هذا المرض، اعتبرت "ان خطورة الوضع ارتفعت قياسا على تاثيرها على الصحة العامة"، ولفتت اللجنة الى الارتفاع الكبير لعدد الحالات وضعف التدابير الوقائية والسيطرة على انتقال العدوى.
أعلنت السعودية وفاة خمسة اشخاص بفيروس كورونا مما يرفع عدد الذى اودى الفيروس بحياتهم الى 168 شخصا فى المملكة اول بؤرة ظهر فيها مصابون به فى 2012.
وفى حصيلتها الاخيرة التى وضعت السبت على موقعها الالكتروني، قالت وزارة الصحة السعودية ان عدد المصابين بالفيروس المسبب لمتلازمة الشرق الاوسط التنفسية بلغ 529 منذ ظهور المرض فى المملكة. وقالت الوزارة ان رجلين فى السابعة والستين من العمر وسيدة فى الثمانين توفوا فى جدة (غرب) العاصمة الاقتصادية للمملكة حيث اثار الاعلان عن عدة حالات مؤخرا هلعا بين السكان وادى الى اقالة مدير مستشفى الملك فهد.
وتوفى رجل فى الحادية والسبعين وآخر فى السابعة والسبعين فى الرياض والمدينة المنورة (غرب) على التوالى.
وعلاوة على السعودية، سجلت اصابات فى الاردن ومصر ولبنان والامارات والولايات المتحدة وهولندا الا ان غالبية المصابين سافروا الى المملكة او عملوا فيها، والاربعاء اعلنت منظمة الصحة العالمية بعد اجتماع طارىء عقدته الثلاثاء حول كورونا ان لا ضرورة لاعلان حالة "طوارىء صحية عامة شاملة"، فى غياب ادلة حول انتقال الفيروس بين البشر.
واكدت المنظمة ان لجنة الطوارىء التى عقدت اجتماعها الرابع حول هذا المرض، اعتبرت "ان خطورة الوضع ارتفعت قياسا على تاثيرها على الصحة العامة"، ولفتت اللجنة الى الارتفاع الكبير لعدد الحالات وضعف التدابير الوقائية والسيطرة على انتقال العدوى.
































التعليقات